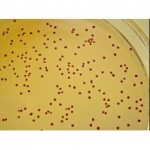
奥玛（唐山）生物工程有限公司

产品列表
-
¥3950/吨河北 石家庄市
-
质量标准:中国蛋鸡料看山东,山东蛋鸡料看天聚;百年目标:专注蛋禽产业,力求精益求精;产品特点:天聚蛋鸡料已领先升级为第三代产品----营养保健型,在全面满足蛋鸡营养需求条件下,常年添加益生素、酶制剂、中草药等功能保......¥6000/吨山东 济南市
-
http://www.china-tianju.com/productsinfo.asp?c=products&ID=2061 或登陆企业网站,搜索“天聚企业集团"实名...¥6000/吨山东 济南市
-
枯草芽孢杆菌,地衣芽孢杆菌,嗜酸乳杆菌,粪链球菌,产朊假丝酵母,酿酒酵母,植物乳杆菌...¥面议/kg河北T 唐山市
-
¥面议/kg河北T 唐山市
-
¥4000/吨河北 石家庄市
-
¥1/kg山东W 潍坊市
-
维持肠道生态平衡,抑制有害菌生长,并且有效分解饲料中的淀粉和蛋白质等大分子物质,释放出蛋鸡易于消化吸收的小分子营养物质,提高饲料的利用率(5-10%),显著提高产蛋率,提升鸡蛋的品质,延长产蛋高峰...¥1/kg山东W 潍坊市
-
¥1/kg山东W 潍坊市
-
¥1/kg山东W 潍坊市
-
改善反刍动物胃肠环境,抑制有害菌生长,并且有效分解饲料中的粗纤维等抗营养因子,释放营养物质,使其能被充分消化吸收,提高饲料的利用率,改善反刍动物的生产性能...¥1/kg山东W 潍坊市
-
¥2270/吨